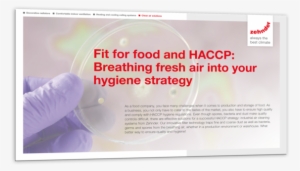
Filters That Effectively Trap Fine And Coarse Dust, - Document #370478

-
Magick - Free Roblox Particle Effect
559*550
8
3
-
Particle Effect Photoshop Png
3000*2000
7
1
-
Particle Effects Vol - Special Effects Gif Png
600*500
8
2
-
Light Particles Png Download - Blurred Lights Effect Png
1375*978
12
8
-
Particle Effects Vol - Portable Network Graphics
404*316
3
1
-
Game Visual Effect Animation Sprite - Animation
600*500
5
1
-
Character Animation And Particle Effects - Painting
1024*576
5
1
-
Particle Impact Dynamic Light Effect - Beige
3031*2163
6
1
-
Sem Photographs Of Polymer Composites Particles
900*352
4
1
-
Particle Effects - Graphic Design
800*449
2
1
-
Smoke Effect Clipart Roblox Particle - Cartoon
640*480
2
1
-
Smoke Effect Clipart Roblox Particle - Circle
640*480
2
1